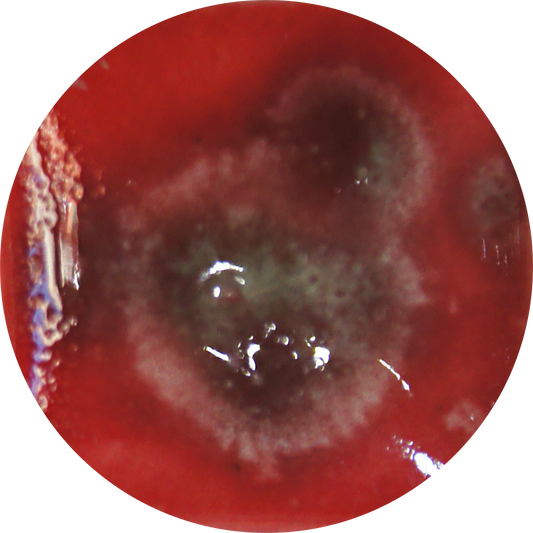
fg084h_big.png

Ceramiq.pl – sklep i szkoła ceramiki dla pasjonatów sztuki
Powtarzalne efekty
Obawiasz się niespodzianek po wypale? My to rozwiązujemy! Nasi eksperci testują i wybierają materiały dla powtarzalnych efektów.
Gotowe do użycia
Prowadzisz warsztaty? Nasze szkliwa i farby minimalizują przygotowania. Otwórz i twórz od razu!
Twoje dopasowane zestawy
Niepewna, co wybrać do lepienia? Nasze gotowe zestawy z kompatybilną gliną i szkliwem oszczędzą Twój cenny czas!
Materiały zawsze na czas
Martwisz się o opóźnienia? My to rozumiemy! Wysyłka w dniu złożenia zamówienia lub następny dzień roboczy.
Odkryj nowości w Ceramiq.pro
Mayco STONEWARE GLAZES "Pink Pearl" 473 ml
Mayco STONEWARE GLAZES "Tidal Wave" 473 ml
Porcelana płynna TWIST - Mustard 5kg
Porcelana płynna TWIST - Gemlik 5kg
Porcelana płynna TWIST - Foca 5kg
Mayco STONEWARE GLAZES "Lilac Speck" 473 ml
Mayco STONEWARE GLAZES "Pink Speck" 473 ml
Mayco STONEWARE GLAZES "Baby Blue Speck" 473 ml
Porcelana Plastyczna SIO2 Begur Rose 5 kg
Porcelana płynna TWIST - Titus 5kg
HIGH FIRE GLAZE BRIGHT BLUE 140 ml
SUPERNOVA GLAZE MIRA 140 ml
VOLCANO GLAZE ARENAL 140 ml
STONEWARE EXOTIC POMEGRANATE 140 ml
3D THIN TRAIL GLAZE H BLUE 60 ml
CRYSTALLITE TERRACOTTA 140 ml
STONEWARE GLAZE PRISM RED 140 ml
STONEWARE EXOTIC MARBLE BROWN 140 ml
FANTASY GLAZE H LADY BIRD 140 ml
STONEWARE EXOTIC SEA AGATE 140 ml
MATT GLAZE H VIOLET 140 ml
HIGH FIRE GLAZE TORO RED 140 ml
FANTASY GLAZE H DALMATION 140 ml
HIGH FIRE EXOTIC SODALITE 140 ml


O Nas
Ceramiq.pro – proste rozwiązania dla Twojej pracowni. Prowadzisz ceramiczne studio, warsztaty albo uczysz w szkole? Wiesz, że najwięcej czasu zabiera nie samo tworzenie, ale przygotowania: odmierzanie proszków, szukanie materiałów, czekanie na dostawy. Właśnie dlatego powstał Ceramiq.pro – sklep ze sprawdzonymi materiałami, gotowymi do użycia. Nie jesteśmy „kolejnym sklepem internetowym”. Jesteśmy częścią Ceramiq – marki, która od lat wspiera ceramików i prowadzi własną szkołę. Dzięki temu znamy realne potrzeby pracowni i proponujemy rozwiązania, które naprawdę ułatwiają pracę.
O nasBestsellery
Najchętniej wybierane przez ceramików
Ceramiq Viral Glaze Czerwona porzeczka
Złoto naszkliwne w płynie 10% - 5 gram
Ceramiq Viral Glaze Drozd Śpiewak
Ceramiq Viral Glaze Przepiórka
Cyklina drewniana R17 "macgyver L"
Ceramiq Viral Glaze Zielony Smok
Ceramiq Viral Glaze Słoneczny Krater
Ceramiq Viral Glaze Piaskowiec nakrapiany
Ceramiq Viral Glaze Salamandra plamista
Dadya ceramic glaze SP1518 118 ml
Cyklina drewniana R8 "Kingsize"
Mayco Specialty Glazes "Light Magma" 473 ml
Ceramiq Viral Glaze Lody miętowe
Glina SiO2 PRAI Biała 40% 0-0,2 mm szamot - 12,5 kg
Turquoise Green ceramic glaze S1020 118 ml
Glina Goerg & Schneider nr 254 - biała 10 kg
Ceramiq Viral Glaze Stracciatella
Glina SiO2 Luna - 12,5 kg
Ceramiq Viral Engobe Błękit
Glina SiO2 PB klasyczna, biała - op. 12,5 kg
Mayco Jungle Gems “Blueberry Bubblegum” 118 ml
Szkliwo płynne Botz Pro 9313 Biały Piryt - 200 ml
Glina Sibelco nr WM 2502 - jasna, 10 kg
Ceramiq Viral Glaze Arktyka
Szkliwo Płynne Botz 9608 Harlekin - 200 ml
Producenci